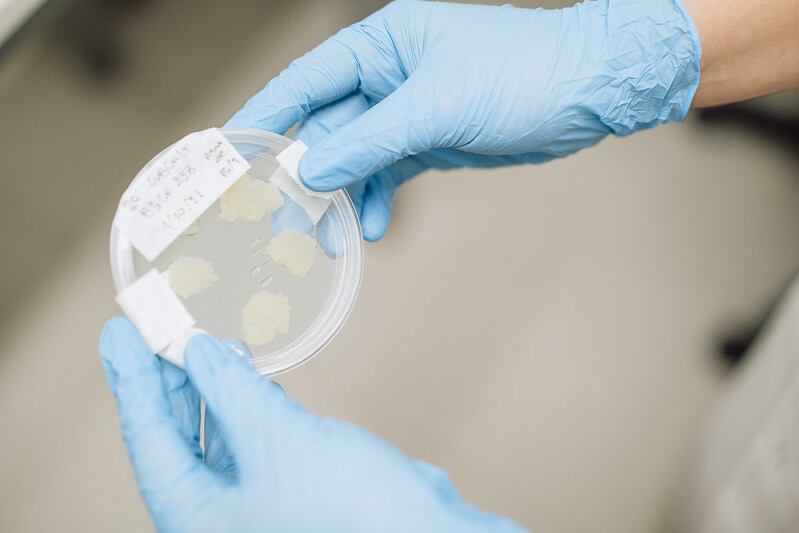

Dairy major Pascual launched its incubation programme for cow-free dairy innovation in partnership with food tech accelerator Eatable Adventures in 2021.
At the time, Pascual Innoventures – the open innovation arm of Spain-headquartered Pascual – said that by supporting cellular agriculture-derived dairy, the company is supporting technology ‘complementary in growth and in applications within the broad industry’. The following year, molecular farming projects were added to the previously dairy-focused agenda.
But for Mylkcubator’s third edition, Pascual is expanding its scope even further. While biosynthetic dairy products are still very much on the table, so are new technologies that have an ‘impact on tangential areas’ for Pascual.
Finding synergies with Pascual’s core business
As a company, Pascual does not only work in dairy via its Leche Pascual division, but also has a strong presence in juice via Bifrutas and Pascual Essential labels.
The business also plays in soy drinks via its Vivesoy brand, and boasts a significant presence in coffee through labels Mocay, Pascual Profesional, and Café Jurado.
The latest edition of Mylkcubator – coined ‘Mylkcubator: More than Milk’ – has been designed to align with these categories. Innovators working across alternatives to coffee, egg, lipids, cocoa, sodium and sweetener replacements, as well as functional ingredients, are encouraged to apply.
“We have expanded our technologies beyond dairy product generation into other areas such as egg production, coffee, lipids, and cocoa, using alternative approaches that leverage various technologies and ingredients – sodium substitutes sweeteners, and functional ingredients – because we aim to seek future-oriented solutions for our company’s core business such as coffee, and the ingredients we use in our products,” Gabriel Torres, director of Pascual Innoventures, told FoodNavigator.
The result is an incubator which claims to be the first global programme dedicated to advancing cellular agriculture technologies and fermentation techniques in the alternative food industry.
What is Mylkcubator looking for in each new area?
According to Mylkcubator, the aim of the programme is to support projects developing technological advances in the fields of cell cultures and fermentation techniques that are generating a ‘disruption’ in the agri-food system.
Working with ‘specialised professionals’ from the Pascual team and partners’ network, the program is designed to help start-ups engage in collaboration models ranging from sweat equity and CAP to commercial agreements, co-creation, technology licensing, investment, and industrial scale-up.

To throw a spotlight on the incubator’s new areas of interest, in the egg alternatives space Pascual and Eatable Adventures are looking for technologies ranging from precision fermentation for proteins, innovative applications of algal proteins, and new approaches using fungal fermentation and plant-based ingredients.
In alt coffee, Mylkcubator is looking for entrepreneurs working with coffee processing robotics, plant-based blends for coffee-like flavours, genetic editing for improved coffee bean properties, and technology that repurposes coffee waste. In alternatives to cocoa, the incubator is on the hunt for technologies such as oat and vegetable fermentation, lab-grown cocoa cell cultivation, and the use of cocoa fruit residues to create beverages.
Other areas of interest include lipid alternatives to palm oil and others linked to environmental degradation. Technologies could range from yeast fermentation for dairy fat to omega-3 microencapsulation, slow-release healthy fats, fat cell cultivation, fermentation of plant by-products for biomass and lipid separation, and precise CO2 fermentation for lipid production.
In the functional ingredients category areas of interest include precision fermentation, enzyme advancements, exosome extraction from milk whey, functional ingredient development with RNA technology, and design using proteomics and computational biology.
Sodium and sweetener replacements are also on their radar, from natural sweeteners made from plant proteins to the use of fermentation to cultivate specific fungi strains, and creating blends with compounds such as stevia, erythritol, or xylitol.
Dairy makes a splash in Mylkcubator 2021-2022
Now in its third year, Mylkcubator boasts an impressive line-up of alumni. Altogether, its two cohorts of start-ups have generated $14.4m (13.55m) of investment.
In 2021, Mylkcubator focused on cellular agriculture for the dairy industry, from cell-based to fermentation and applied technologies. The cohort included Barcelona-based Real Deal Milk which makes casein and whey via precision fermentation, and India-headquartered Zero Cow Factory, which claimed at the time to be developing the world’s first A2 milk protein via microbial fermentation.
Another start-up from Mylkcubator’s first cohort is South Africa-based De Novo Dairy (now De Novo Foodlabs), which is similarly leveraging precision fermentation technology to produce animal-free dairy. US-based M2 Factors – a subsidiary of 108Labs – which is working to reduce the cost of cell-cultured dairy production, also took part.
In 2022, Mylkcubator expanded its reach to include molecular farming projects. The cohort included Portugal’s PFx Biotech, which develops human milk proteins for use in paediatric and advanced nutrition; and Dutch molecular farming start-up Miruku, which produced proteins and fats in plants.
Israeli start-up Maolac also took part in the second cohort. The start-up makes functional ingredients from bovine colostrum that are bioequivalent to those found in breast milk.
Argentinian start-up Ergo Bioscience, which expresses myoglobin and casein from carrot cell cultures, was also selected, as was Nutropy, a French company creating caseins and dairy fatty acids with precision fermentation.
Pascual Innoventures chose to invest in De Novo Dairy, Zero Cow Factory, Ergo BioScience, and Maolac.





